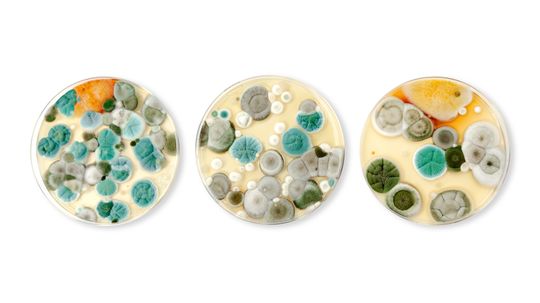
12 Types of Mold That'll Make You Want to Deep-Clean Your House ASAP

Recent Contributions
Ranking the smallest economies in the world sounds simple, but it opens a window into how the global economy really works. When you rank smallest economies by nominal GDP, you are looking at gross domestic product at current prices, not quality of life, political stability, or human resilience.
Animals with opposable thumbs stand out in the animal kingdom because they can grasp, hold, and manipulate objects with precision.
By Nico Avelle
Identifying the longest country name might sound like a simple trivia challenge, but it actually reveals a lot about history, politics, and identity.
Advertisement
The biggest pharmaceutical companies play a central role in the global economy by developing drugs, vaccines, and medical solutions that shape modern healthcare.
Declaring the best countries for education is one of those phrases that sounds simple until you start asking what "best" really means. On the global stage, education rankings can weigh a mix of public education quality, university strength, and how well students perform in reading, mathematics, and science.
The biggest tech companies dominate the modern technology sector, shaping how people use computers, smartphones, and online services every day.
Solitary animals make up a large and often overlooked part of the animal kingdom.
By Nico Avelle
Advertisement
Looking at the countries near Italy helps explain why the Italian Republic has played such a central role in European history, trade and culture.
Different types of mold show up in many indoor environments, especially where moisture problems allow mold growth to take hold. Mold spores float through indoor air all the time, but when they land on a wet surface with organic material or cellulose rich materials, they can form a mold colony.
Searches for the cheapest golden visa often mix two very different things: residency by investment and citizenship by investment.
Commensalism examples show how different species interact in nature. In a commensal relationship, one organism benefits while the other organism remains unaffected—neither helped nor harmed.
By Nico Avelle
Advertisement
In a state packed with deserts, rivers, forests and coastlines, invasive species in California are a serious threat to the plants and animals that evolved here.
The biggest oil producer in the world is the United States. That has been true since 2018, when U.S. crude oil production moved past every other country and has generally increased on the back of shale oil, hydraulic fracturing and horizontal drilling
What drink has the most caffeine? To answer, you first have to choose a measuring stick.
When people ask how many countries start with the letter Y, the answer is surprisingly simple: There is only one country whose English name begins with that letter.
Advertisement
Debates about the worst NBA team usually start with the win-loss record, but as of publishing, the standings, power rankings and advanced stats all point in the same direction.
By Isla Brevant
Coral reefs around the world are tiny animal-built cities that power some of the planet's richest ocean ecosystems. Even though coral reefs cover less than 1 percent of the ocean floor, the coral reef ecosystem supports about one-quarter of all marine species and helps sustain local communities, coastal populations and major tourism economies around the world.
By Nico Avelle
A list of Einstein visa recipients is never truly complete, because public disclosure of individual EB-1 and EB-1A approvals is rare under privacy rules. Still, a handful of people have publicly confirmed the visa, appeared in court records or were widely reported as recipients of the so-called "Einstein visa" or "genius visa."
The most expensive data centers are getting pricier because the digital world now wants more computing, more cooling, and more electricity all at once.
Advertisement
There are actually over 120 species of birds that don't have the ability to fly, for various evolutionary reasons. These seven are some of the most recognizable
By Katie Carman
The smallest lizard in the world depends on what part of the animal you measure. Scientists usually compare lizards by snout-to-vent length, or SVL, which measures body length from the tip of the snout to the opening beneath the tail.
By Nico Avelle
Where do tacos originate from? It seems simple until you look closely at the tortilla in your hand. The short answer is that tacos come from Mexico, but the longer answer runs through Indigenous people, Mexican miners, street vendors, and fast food chains that turned a local staple into a global dish.
In campaign finance, though, PAC vs. Super PAC designation marks a major legal divide.
Advertisement
The biggest Civil War battles produced the most casualties, drew in the largest armies, or changed the direction of the war in a lasting way.
Whisper Valley is a neighborhood in northeast Austin that treats energy, land, and everyday living as parts of the same system. In this master planned community near Manor, Texas, the pitch is not just a new home in a growing part of the city.